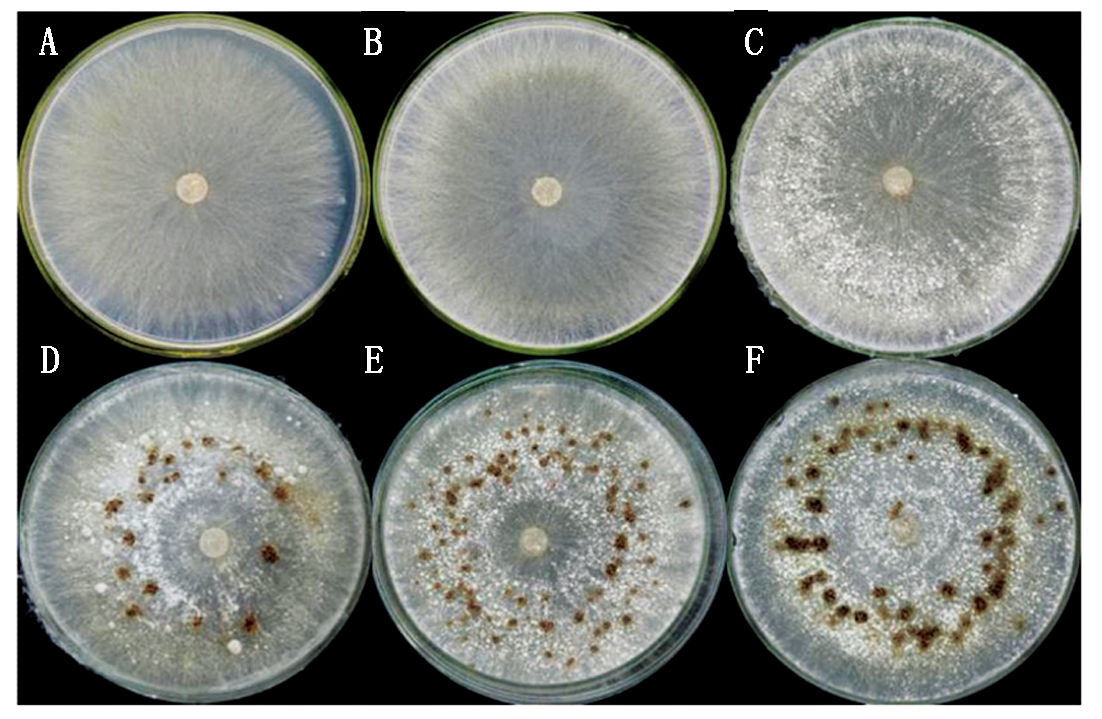

摘要:通过生物信息学方法及表达分析对水稻纹枯病菌谷胱甘肽S转移酶基因(Rsgst)的功能进行探索。通过水稻纹枯病菌RSIADB基因组数据库查找Rsgst序列,确定该基因在水稻纹枯病菌基因组中的精确位置。利用生物信息学软件预测Rsgst编码蛋白氨基酸序列的基本信息,并使用MEGA 5.0软件构建同源蛋白的系统发育树,最后用qRT-PCR检测Rsgst在菌核发育过程中的基因表达量,同时测定GST的酶活性。结果表明,Rsgst全长1 207 bp,该基因共编码277个氨基酸残基,其编码蛋白分子量为30.90 ku,理论等电点为9.42。该蛋白二级结构中以α-螺旋为主,占41.52%。系统发育树表明,水稻纹枯病菌GST蛋白与担子菌类玉米丝黑穗病菌GST蛋白亲缘关系最近。qRT-PCR结果表明,Rsgst在水稻纹枯病菌菌核发育过程中表达量不断上调,基因最高表达量是在第60小时,为7.64,而Rsgst的最高酶活性是在第5 天,其酶活为0.375 U/μg。结果可为预测水稻纹枯病菌中Rsgst基因的功能奠定基础。
关键词:水稻纹枯病菌;谷胱甘肽S-转移酶;菌核发育;酶活测定;基因组定位
水稻纹枯病(Rice sheath blight)是世界性的水稻真菌病害之一[1]。近年来,随着水稻矮秆多蘖品种的密植以及氮肥过量施用等原因,水稻纹枯病逐渐成为危害水稻生产的第一大病害[2],每年可导致数亿公斤水稻产量的损失,严重时可以使水稻减产50%,甚至绝收[3]。根据我国农技中心(http://www.natesc.agri.cn/)的预测,水稻纹枯病今年在全国稻区发生面积将达到1 766.67万hm2,在南方稻区发病严重。
水稻纹枯病的病原菌为立枯丝核菌 (R.solani AG1-IA),该菌在自然条件下不产生有性孢子,而是产生菌丝和菌核[4]。菌核是由菌丝纠结而成的坚硬而且高度黑色素化的结构。菌核可以通过残留在土壤中进行越冬,是病害初侵染的主要来源[5]。田间菌核残留量与纹枯病的发病情况成正比,降低田间的菌核量可有效减少水稻纹枯病的发生[6]。因此,研究水稻纹枯病菌菌核发育的关键因子,探索调节菌核发育的基因,对于防治水稻纹枯病具有重要的意义。
菌核发育过程与细胞的氧化胁迫有关[7]。当真菌遭受氧化胁迫时,细胞中的活性氧物质(Reactive oxygen species,ROS)含量会上升,ROS会激活细胞内的信号转导,使未分化的菌丝开始分化形成菌核结构以抵御细胞中过量的ROS,减少ROS对细胞的损害,以保存真菌的生命力。当生物细胞响应氧化胁迫反应时,一些酶(如过氧化氢酶(CAT)、超氧化物歧化酶(SOD)和过氧化物酶(POD))以及非酶类保护系统(如谷胱甘肽(GSH)和硫氧还蛋白)会保护细胞免受伤害[8]。
谷胱甘肽(Glutathione,GSH)最初是在1888年由法国科学家Rey-Pailhade在酵母中发现,由L-谷氨酸、L-半胱氨酸和甘氨酸组成,是广泛存在于生物体内具有重要生理功能的三肽化合物[9]。GSH结构中活泼的巯基基团与自由基结合,从而对于细胞清除活性氧起到重要作用[10],而在这个过程中谷胱甘肽S-转移酶(Glutathione S-transferase,GST)起了重要的催化作用[11]。
GST是一种超家族蛋白酶,具有解毒和抗氧化功能[12],广泛存在于各种生物体的各组织细胞内。真菌的GST在结构和功能上分化程度大,已报道真菌GST主要参与氧化应激、解毒等生物学进程。魏涛[13]研究发现,在烟曲霉(Aspergillus fumigatus)GST家族中,不同GST蛋白的底物谱有很大差异,对于同一底物酶活性也有很大差异,说明GST蛋白的功能出现了分化;张媛[14]研究发现,在产黄青霉(Penicillium chrysogenum)中,GST的编码基因(PcgstA、PcgstB和PcgstC)的氨基酸序列都具有保守的GST功能域,但在结构和功能上仍存在差异。Cho等[15]对裂殖酵母(Schizosaccharomyces pombe)进行氯化汞等胁迫处理诱导了GST基因表达,说明GST基因参与氧化胁迫反应。此外,Veal等[16]对裂殖酵母的3个GST基因进行突变后,发现突变体比野生型对氟康唑更加敏感,表明GST基因参与了抗真菌药物的解毒过程。
前期笔者通过RNAseq技术研究了水稻纹枯病菌菌核发育过程的基因差异表达,通过生物信息学分析发现一个编码GST的Unigene差异表达显著。本研究对Rsgst进行生物信息学和系统进化分析,并进一步研究该基因在菌核形成过程的表达模式和GST酶活变化趋势,旨在为进一步研究该基因的功能提供理论依据。
1.1.1 供试菌株 水稻纹枯病病菌(R.solani AG1-IA)野生型菌株GD-118由广东省微生物信号与作物病害防控重点实验室保存。
1.1.2 菌株的培养 用打孔器在已活化的水稻纹枯病菌菌落边缘打取菌块,将菌块接种在铺好玻璃纸的PDA平板上,在25 ℃下进行培养,分别在36,48,60 h刮取培养皿的菌丝,在72 h及5 ,7 d用灭菌的镊子收集培养皿上的菌核。每个样品设置3个重复,样品收集后放于-80 ℃保存备用。
1.1.3 主要试剂 真菌RNA提取试剂盒(货号:9767)、反转录试剂盒(货号:AT341)、qRT-PCR试剂盒(货号:AT341)均购自大连TaKaRa公司。谷胱甘肽S转移酶(GST)测试盒(货号:A004)购自南京建成生物工程研究所。
1.2.1 水稻纹枯病病菌GST基因(Rsgst)生物信息学分析 通过已公布的水稻纹枯病菌基因组数据库(RSIADB,http://genedenovoweb.ticp.net:81/rsia/index.php?m=index&f=index)查找Rsgst序列,确定该基因在水稻纹枯病菌基因组中的精确位置。核酸及氨基酸序列的分析、理化性质分析利用ProtParam(http://www.expasy.org/tools/protparam.html)进行。利用ScanProsite(http://prosite.expasy.org/scanprosite/)预测其所包含的功能域。利用KinasePhos(http://kinasephos.mbc.nctu.edu.tw/)软件对其蛋白质序列进行激酶磷酸化修饰位点预测。利用COILS(http://www.ch.embnet.org/software/COILS_form.html)软件对序列进行卷曲螺旋预测。利用PSIPRED(http://bioinf.cs.ucl.ac.uk/psipred/)在线软件对GST蛋白的二级结构进行分析。通过PHYRE2 (http://www.sbg.bio.ic.ac.uk/phyre2/html/page.cgi?id=index)在线服务器对GST蛋白质的三维结构进行了预测分析。通过对半知菌类立枯丝核菌的GST基因编码的氨基酸序列与烟曲霉(A.fumigatus)、禾谷镰孢菌(Fusarium graminearum)、酿酒酵母(Saccharomyces cerevisiae)、扩展青霉菌(Penicillium expansum)、绿僵菌(Metarhizium anisopliae)、小孢根霉(Rhizopus microsporus)、胶孢炭疽菌(Colletotrichum gloeosporioides)、玉米丝黑穗病菌(S.reilianum)和褐座坚壳菌(Rosellinia necatrix)等9类病原菌进行氨基酸序列多重比对,利用MEGA 5.0的临近法构建系统发育树,设置了1 000次重复,其他均为默认设置。
1.2.2 水稻纹枯病病菌菌核发育过程中Rsgst的表达分析 RNA提取与反转录:真菌总RNA的提取步骤参照产品说明书。RNA的质量用1%琼脂糖凝胶电泳检测,RNA的纯度用Nanodrop 2000微量紫外分光光度计(Thermo Scientific,Wilmington,DE)进行检测。RNA的反转录:取1 μg RNA,加入4 μL 5×TransScript® ALL-in-One SuperMix for qPCR和1 μL gDNA Remover,最终加无RNase水至20 μL。轻轻混匀后,42 ℃孵育15 min,再在85 ℃下加热5 s。
荧光定量PCR分析:根据该基因的CDS全长序列设计荧光定量引物RsgstF(5′-ATATACGCCTACCTAAGC-3′)和 RsgstR(5′-CTTGACAGTGACCATATTG-3′)。qPCR反应体系如下,10 μL 2×TransScript®Top Green qPCR SuperMix,0.4 μL引 物(10 μmol/L),2 μL cDNA模板,加ddH2O定容至20 μL。反应程序设定如下:预变性 94 ℃ 30 s;变性94 ℃,5 s,退火55 ℃,15 s,延伸72 ℃,10 s,共40个循环。所有试验都设3次重复。样品间基因相对定量比较用2-ΔΔCt法进行分析,相对表达量的公式是R=2-(ΔCt(目的基因)-ΔCt(内参基因) ),ΔΔCt=(Ct(目的基因)-Ct(内参基因))-(Ct(校正)-Ct(内参基因))。基因表达水平通过水稻纹枯病菌的三磷酸甘油醛脱氢酶(Glyceraldehyde-3-phosphate dehydrogenase)基因进行校正。
1.2.3 水稻纹枯病病菌菌核发育过程中GST酶活测定 根据谷胱甘肽转移酶(GST)试剂盒上的步骤进行操作:称量0.3 g样品用50 mmol/L磷-EDTA溶液冲洗2~3次后,将样品放入研钵中,加入液氮研磨成粉状,按照1∶2(m/V)体系加入50 mmol/L磷酸缓冲液(pH=7),继续研磨,将研磨后的悬浮液在15 000 r/min离心10 min。取100 μL上清液,加入300 μL基质液,充分混匀后在37 ℃水浴30 min,再加入2 mL试剂二(试剂盒提供),混匀后以3 500 r/min离心10 min,取上清液作显色反应。对照管在水浴后加入100 μL上清液,其他操作步骤相同。取上述上清液2 mL分别加入2 mL试剂三(试剂盒提供)和0.5 mL试剂四(试剂盒提供),混匀后室温静置15 min,在紫外分光光度计412 nm处进行比色。以加入2 mL的20 μmol/L GSH标准品作为标准管,以加入2 mL的试剂二(试剂盒提供)作为空白管,其他操作步骤相同。所有试验设置3次重复。
组织中GST活力公式为:
GST活力
×标准品浓度×反应稀释倍数÷反应时间÷取样量÷待测样品蛋白浓度。
1.2.4 数据分析 所得的数据用SPSS 13.0软件的方差分析进行统计,P<0.05为差异显著。
2.1.1 Rsgst在基因组中定位 在RSIADB网站搜索Rsgst在水稻纹枯病病原菌基因组中的定位,该基因在NCBI的登录号为443926675,基因全长1 207 bp,CDS全长为834 bp,共编码277个氨基酸。该基因在病原菌与寄主互作蛋白数据库(Pathogen-hostinteractiondatabase,PHI)和碳水化合物活性酶类数据库(CAZy)没有得到注释。该基因在水稻纹枯病菌基因组scaffold1正链的2 084 816-2 086 022位置。
2.1.2 理化性质分析 利用ProtParam在线分析工具分析GST蛋白的理化性质,结果发现,该蛋白质含有277个氨基酸残基,分子量为30.90 ku,理论等电点为9.42,预测该蛋白质在280 nm处的吸光度为1.031~1.039,不稳定系数为48.71,脂肪系数为88.74,蛋白质的平均疏水性为-0.253。
如表1所示,组成GST蛋白的氨基酸主要有酸性氨基酸、碱性氨基酸、非极性R基氨基酸和不带电荷的极性R基氨基酸4种。其中,以亮氨酸(Leu)比例最高,为12.3%;色氨酸(Trp)比例最低,为0.7%。从氨基酸所属种类来看,GST蛋白所占有的非极性R基氨基酸比例最高,为47%;而酸性氨基酸所占比例最低,为10.5%。
2.1.3 结构域功能分析 利用ScanProsite软件对GST蛋白序列进行分析,结果显示,该序列ID为USERSEQ1,GST序列包含2个保守的结构域,分别是C-端结构域(Pfam 登录号:PF00043.19)和N-端结构域(Pfam 登录号:PF02798.14)。GST编码蛋白的功能域中含有2个结构蛋白,在N端含有一个GST-NTER结构蛋白,位于序列第7-93位氨基酸;在C端含有一个GST-CTER结构蛋白,位于序列第101-202位氨基酸(图1)。
表1 GST蛋白的氨基酸的组成
Tab.1 Amino acid composition of GST protein

氨基酸种类Typesofaminoacids数量/个Number所占比例/%Ratio酸性氨基酸谷氨酸Glu134.7Acidicaminoacid天冬氨酸Asp165.8碱性氨基酸精氨酸Arg207.2Basicaminoacid赖氨酸Lys217.6组氨酸His51.8非极性R基氨基酸丙氨酸Ala217.6NonpolarRaminoacid缬氨酸Val176.1亮氨酸Leu3412.3异亮氨酸Ile114.0色氨酸Trp20.7甲硫氨酸Met51.8苯丙氨酸Phe103.6酪氨酸Tyr145.1脯氨酸Pro165.8极性R基氨基酸甘氨酸Gly227.9PolarRaminoacid天冬酰胺Asn72.5谷氨酰胺Gln41.4丝氨酸Ser196.9苏氨酸Thr155.4半胱氨酸Cys51.8
2.1.4 激酶磷酸化修饰位点预测 利用KinasePhos软件对GST蛋白序列进行激酶磷酸化修饰位点预测,结果显示,有2个丝氨酸(S)激酶、3个酪氨酸(Y)激酶潜在的磷酸化位点,0个苏氨酸(T)激酶磷酸化位点,且在氨基酸序列221位置上有一个激酶磷酸化位点可以催化2种激酶,分别为蛋白激酶G(Protein kinase G,PKG)和细胞周期蛋白依赖性激酶(Cell division cycle 2,cdc2)。
2.1.5 蛋白高级结构预测 利用COILS软件对序列进行卷曲螺旋预测,结果发现,该蛋白没有明显卷曲螺旋。利用PSIPRED在线软件对GST蛋白的二级结构进行分析,结果如图2所示,发现GST中氨基酸残基组成以α-螺旋为主,占41.52%,有32个氨基酸残基组成β-折叠,占11.55%。

图1 GST蛋白的结构域
Fig.1 The protein domain of GST


图2 GST蛋白二级结构图示
Fig.2 The model of the secondary structure of GST protein
通过PHYRE2在线服务器对GST蛋白质的三维结构进行了预测分析,获得了该蛋白质的三维结构模型(图3)。

图3 预测的GST蛋白三维结构
Fig.3 The predicted tertiary structure of GST
2.1.6 系统发育分析 通过MEGA 5.0构建的系统进化树表明,立枯丝核菌不同融合群之间GST的氨基酸(R.Solani AG-1 IA)序列都聚在一个大的分支中,其中,水稻纹枯病菌单独一个分支,而立枯丝核菌融合群3和融合群8亲缘关系比较近;立枯丝核菌GST与担子菌类玉米丝黑穗病菌(Sporisorium reilianum)GST亲缘关系最近,与半知菌类烟曲霉(A.fumigatus)、禾谷镰孢菌(F.graminearum)、胶孢炭疽菌(C.gloeosporioides)GST亲缘关系次之,与小孢根霉(R.microsporus)GST亲缘关系最远(图4)。

图4 GST的系统发育树
Fig.4 Phylogenetic tree of GST
2.2.1 菌核发育过程样品收集和RNA提取 本研究选定立枯丝核菌菌核发育过程中6个阶段的病菌样品,结果如图5所示,初期在培养皿上长出白色菌丝,在48 h时菌丝长满培养皿,之后菌丝逐渐纠结在一起,在60 h时开始形成白色菌核。菌核不断发育积累黑色素,在72 h时已有黑核出现,此后菌核继续发育成质地坚硬的黑核,在7 d时黑核发育成熟。
A.菌核发育36 h;B.菌核发育48 h;C.菌核发育60 h;D.菌核发育72 h;E.菌核发育5 d;F.菌核发育7 d。
A.Sclerotial development 36 h; B.Sclerotial development 48 h;C.Sclerotial development 60 h;D.Sclerotial development 72 h;E.Sclerotial development 5 d;F.Sclerotial development 7 d.
图5 水稻纹枯病菌菌核发育过程的6个阶段
Fig.5 Six stages of sclerotial development of R.solani AG1-IA
分别提取了上述样品的RNA,用1%琼脂糖凝胶电泳检测其质量,所提取的RNA条带清晰、完整,无拖带和降解;RNA的纯度用Nanodrop 2000微量紫外分光光度计(Thermo Scientific,Wilmington,DE)检测,结果表明,OD260/280的值为1.9~2.1,说明RNA质量和纯度合格,可以用于后续试验。
2.2.2 水稻纹枯病菌菌核发育过程中Rsgst表达规律 利用qRT-PCR检测Rsgst在菌核发育过程中的表达规律,如图6所示,Rsgst在菌丝逐渐发育过程中表达量逐渐上升,在60 h时(白核开始发育时期)达到最高表达量(7.64),该阶段表达量约为36 h时的7.64倍,之后该基因的表达量呈逐渐下调趋势,在黑核发育成熟时(7 d)表达量达到最低,为0.41。

a、b、c、d、e为方差分析结果,不同字母表示差异显著(P<0.05)。图7同。
a,b,c,d and e are the result of variance analysis,different letter showed significant difference(P<0.05).The same as Fig.7.
图6 Rsgst在6个阶段的表达量
Fig.6 The expression of Rsgst in six stages
利用GST酶活测定试剂盒测定水稻纹枯病菌菌核发育过程中GST酶活性,结果如图7所示,在36 h时GST的酶活性为0.108 U/μg;随着菌核不断发育,GST的酶活性大致呈增长趋势,在第5天时GST的酶活性最高,达到了0.375 U/μg;随后该酶的活性迅速降低,在第7天酶活性仅为0.235 U/μg。

图7 6个阶段的GST酶活
Fig.7 The activity of GST in six stages
GST是一类超家族蛋白酶。在哺乳动物中,GST可以根据一级序列被划分为8个主要亚家族[17]。在真菌中,GST很难分类,因为无论是在结构上还是在功能上,GST都具有多样性[18]。因此,真菌中主要根据谷胱甘肽转移酶催化过程中催化残基的类型进行划分,分为酪氨酸催化(Tyr-)、丝氨酸催化(Ser-)、半胱氨酸催化(Cys-)三大类[19]。对水稻纹枯病菌GST蛋白激酶磷酸化修饰位点进行预测,结果发现,有丝氨酸/酪氨酸激酶修饰位点,因此,可以推测该菌的GST蛋白是酪氨酸催化(Tyr-)/丝氨酸催化(Ser-)蛋白酶家族成员。从遗传进化树的结果也可以发现,立枯丝核菌不同融合群的GST氨基酸序列聚在一个大分支中,说明它们的氨基酸序列中有些序列相对保守,立枯丝核菌GST与担子菌类的玉米丝黑穗病菌(S.reilianum)GST亲缘关系最近,推测是同一家族成员。在结构域功能分析中,结果发现,水稻纹枯病菌的GST序列包含2个保守的结构域,分别是C-端结构域和N-端结构域。其中,N端结构域含有G位点能够特异性与GSH结合,C端结构域含有H位点与特异性结合底物有关[20]。推测这2个结构域对于GST行使其功能催化GSH与底物结合来清除活性氧有作用。
对水稻纹枯病菌菌核发育6个阶段的GST酶活进行测定,结果发现,在菌丝阶段该酶的活性逐渐上升,在白核转化为黑核阶段(5 d)活性达到最高峰,qRT-PCR结果发现Rsgst在菌核发育初期(60 h)时的表达量最高。本研究发现,GST酶蛋白的活性和基因的表达趋势不一致,这与戴瀚洋等[21]结果类似,其原因可能是因为GST是一种超基因家族酶,有多个基因共同调节其活性变化。Fujimiya等[22]也发现,人类肝脏中GST mRNA的表达与活性的相关性与GST的基因型有关,不同基因型的酶蛋白mRNA的表达量与酶活性相关性有显著差异。此外,mRNA转录后的调控和翻译后的修饰都可能导致mRNA的表达水平和蛋白酶活力水平不一致[23]。但在这个过程中,GST蛋白的表达和活性都出现了显著变化,说明GST基因响应了菌核发育过程。
GST基因响应了菌核的发育过程,可能是对ROS进行了调节的结果。已有研究表明,ROS可以诱导菌核的发育[7,24]。在细胞产生的活性氧物质中,
和H2O2是2种最常见的活性氧物质
在丝核菌菌核未分化阶段产生速率最大,在菌核发育成熟时达到最低值;而H2O2在未分化阶段产生速率最小,在菌核不断发育初期至中期达到最高[25]。在真菌中这2种活性氧物质共同调节菌核的分化[7]。本研究中,GST酶活高峰期滞后于
和H2O2高峰期,推测在菌核发育初期时,
等物质含量不断增加对细胞产生毒害作用,此时细胞中的SOD等酶活性升高将
转化为H2O2,再通过GST酶量的不断增加,从而将H2O2等活性氧物质分解[26],以减少这些有毒物质对生物体的损伤。
在小鼠睾丸中研究发现,谷胱甘肽抗氧化系统共同参与了体内自由基代谢的调节,在小鼠氧化应激时,GSH可以作为GST或者GPx的底物清除小鼠体内的氧自由基[27]。在植物中研究发现,当植物受到低温胁迫时,活性氧含量上升,GST会催化GSH与膜脂过氧化物结合,从而使植物的细胞减少损伤[28]。由此推测,GST通过催化GSH与活性氧结合从而来消除活性氧。而到了菌核发育的成熟阶段,菌核的形态不再变化,菌核作为一个休眠结构,此时细胞中的活性氧物质含量不断降低,因此在成熟阶段,菌核中产生的GST的量也相对减少了。Zhou等[29]在研究HL-60细胞凋亡过程中发现,GST和ROS存在明显的剂量效应关系,细胞内ROS水平不断上升,GST水平不断降低,细胞抗氧化能力减弱,导致死亡。本研究发现,在菌核成熟时GST表达量逐渐下降,这表明了水稻纹枯病菌在菌核发育过程通过产生GST来平衡细胞中的有毒活性氧物质,对菌核的发育具有调节作用。因此,推测在丝状真菌中GST作为一种抗氧化剂通过调节活性氧代谢来响应菌核发育,但GST如何调节活性氧代谢来调节菌核发育还有待于进一步研究。
参考文献:
[1] Chen X J,Li L L,Zhang Y,et al.Functional analysis of polygalacturonase gene RsPG2 from Rhizoctonia solani,the pathogen of rice sheath blight[J].European Journal of Plant Pathology,2017,149(2):491-502.
[2] 李 涛,路雪君,廖晓兰,等.水稻纹枯病的发生及其防治策略[J].江西农业学报,2010,22(9):91-93.
[3] 杨迎青,杨 媚,兰 波,等.水稻纹枯病菌致病机理的研究进展[J].中国农学通报,2014(28):245-250.
[4] 张正禹,董文汉,包文静,等.立枯丝核菌AG-1IA对水稻致病力及粗毒素活性的测定方法研究[J].植物病理学报,2017,47(1):82-91.
[5] 蔡国雄.水稻化学农药减量控害技术实践与推广[J].农家科技,2017(4):24-25.
[6] 苏 品.稻鸭种养生态系统抑制水稻纹枯病的发生流行规律及拮抗菌SU8生防潜力研究[D].长沙:湖南农业大学,2012.
[7] Georgiou C D,Patsoukis N,Papapostolou I,et al.Sclerotial metamorphosis in filamentous fungi is induced by oxidative stress[J].Integrative and Comparative Biology,2006,46(6):691-712.
[8] Zhang Z,Wang J Y,Chai R Y,et al.An S-(hydroxymethyl) glutathione dehydrogenase is involved in conidiation and full virulence in the rice blast fungus magnaporthe oryzae[J].PLoS One,2015,10(3):e120627.
[9] 王玮玮,唐 亮,周文龙,等.谷胱甘肽生物合成及代谢相关酶的研究进展[J].中国生物工程杂志,2014,34(7):89-95.
[10] 贾 贞,王 丹,游 松.谷胱甘肽的研究进展[J].沈阳药科大学学报,2009(3):238-242.
[11] Ohnuma T,Anan E,Hoashi R,et al.Dietary diacetylene falcarindiol induces phase 2 Drug-Metabolizing enzymes and blocks Carbon Tetrachloride-Induced hepatotoxicity in mice through suppression of lipid peroxidation[J].Biological & Pharmaceutical Bulletin,2011,34(3):371-378.
[12] Nahar K,Hasanuzzaman M,Alam M M,et al.Roles of exogenous glutathione in antioxidant defense system and methylglyoxal detoxification during salt stress in mung bean[J].Biologia Plantarum,2015,59(4):745-756.
[13] 魏 涛.真菌谷胱甘肽转移酶(GST)基因家庭的进化与功能分化研究[D].北京:中国科学院大学,2011.
[14] 张 媛.产黄青霉谷胱甘肽转移酶基因的克隆、表达与功能研究[D].石家庄:河北师范大学,2007.
[15] Cho Y W,Park E H,Fuchs J A,et al.A second stress-inducible glutathione S-transferase gene from Schizosaccharomyces pombe[J].Biochimica et Biophysica acta,2002,1574(3):399-402.
[16] Veal E A,Toone W M,Jones N,et al.Distinct roles for glutathione S-transferases in the oxidative stress response in Schizosaccharomyces pombe[J].Journal of Biological Chemistry,2002,277(38):35523-35531.
[17] 胡晓明.家蚕雄蛾触角特异谷胱甘肽-S-转移酶BmGSTD4的基因克隆、表达及功能研究[D].重庆:西南大学,2012.
[18] Mcgoldrick S,O′sullivan S M,Sheehan D.glutathione transferase-like proteins encoded in genomes of yeasts and fungi:insights into evolution of a multifunctional protein superfamily[J].FEMS Microbiology Letters,2005,242(1):1-12.
[19] 马萧萧.酵母谷胱甘肽转移酶Gtt2和甲硫氨酸亚砜还原酶Mxr1的结构与功能研究[D].合肥:中国科学技术大学,2011.
[20] 马立功,孟庆林,张匀华,等.向日葵谷胱甘肽-S-转移酶基因的克隆及抗病功能研究[J].中国油料作物学报,2015,37(5):635-643.
[21] 戴瀚洋,孙 洋,柏立新,等.亚致死浓度甲维盐胁迫对甜菜夜蛾幼虫解毒酶系活力及其相关基因表达量的影响[J].棉花学报,2015,27(2):149-158.
[22] Fujimiya T,Kobayashi Y,Aoki T,et al.Effect of the GSTM1 null genotype on glutathione S-transferase (GST) activity in patients with non-viral liver tumors[J].Showa Univ J Med Sci,2017,28(2):113-121.
[23] 肖广侠,徐文远,贾 磊,等.悬浮物对褐牙鲆肌肉抗氧化酶活性及相关基因表达的影响[J].海洋科学进展,2016,34(4):542-552.
[24] Feng S J,Shu C W,Wang C J,et al.Survival of rhizoctonia solani AG-1 IA,the causal agent of rice sheath blight,under different environmental conditions[J].Journal of Phytopathology,2017,165(1):44-52.
[25] 马亚男.Rhizoctonia spp.菌核分化不同阶段活性氧代谢及相关酶变化[D].泰安:山东农业大学,2011.
[26] 秦 勇.细胞内ROS水平改变对细胞活性及相关信号传导途径的影响[D].杭州:浙江大学,2012.
[27] 李素娟,邢艳刚,薛星晨,等.氟对小鼠睾丸谷胱甘肽抗氧化系统的影响[J].畜牧兽医学报,2017,48(5):954-962.
[28] 张 雪,陶 磊,乔 晟,等.谷胱甘肽转移酶在植物抵抗非生物胁迫方面的角色[J].中国生物工程杂志,2017,37(3):92-98.
[29] Zhou Y L,Lü Y P,Qiu L N,et al.Mechanism of sodium nitroprusside-induced apoptosis in K562 cell line[J].Journal of Experimental Hematology,2005,13(6):983.
Abstract:The aim of this study is to provide the basic for the exploration of Rsgst genes by bioinformatics and gene expression analysis.Based on the R.solani AG1-IA genome database RSIADB,the sequence of Rsgst gene was found.Basic information of the GST amino acid sequence was predicted by several softwares,and a phylogenetic tree was constructed using MEGA 5.0 software.qRT-PCR was used to detect the gene expression levels during the progress of sclerotial development of R.solani AG1-IA,and the GST activity was measured simultaneously.The results showed that the full length of Rsgst was 1 207 bp ,and the gene encodes 277 amino acid residues.The molecular weight of GST was 30.90 ku and the theoretical isoelectric point was 9.42.The secondary structure of this protein was mainly consisted by α-helix which accounted for 41.52%.The phylogenetic tree showed that the R.solani GST was more closely related to Sporisorium reilianum GST.qRT-PCR indicated that the expression of Rsgst was upregulated during the sclerotial development with the highest gene expression at 60 h,which was 7.64,and the maximal activity of GST was 0.375 U/μg at the 5th day.These results are significant to decipher the functions of Rsgst in R.solani AG1-IA.
Key words:Rhizoctonia solani;Glutathione S-transferase;Sclerotial development;Enzyme activity determination;Genomic location
收稿日期:2017-11-20
基金项目:广东省自然科学基金(博士启动)项目(2016A030310454);国家自然科学基金项目(31271994)
中图分类号:S432.1;Q78
文献标识码:A
文章编号:1000-7091(2018)01-0045-07
doi:10.7668/hbnxb.2018.01.008